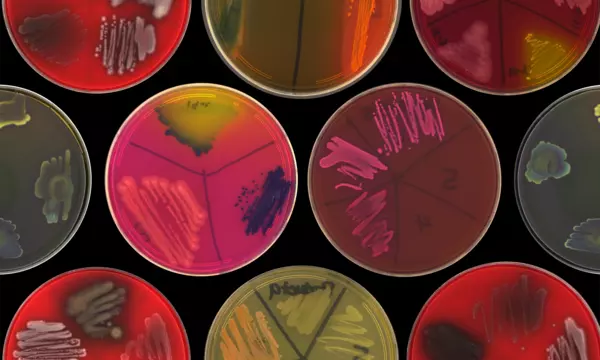

Biosystems and Biomaterials Division
BBD's mission is to foster innovation and build confidence in quantitative biology and biomaterial measurements across government and industry in support of the bio-economy.
Welcome to the Biosystems and Biomaterials Division
BBD is focused on advancing biometrology, standards, and technologies to foster innovation and accelerate the translation and commercialization of emerging biotechnologies in support of the bioeconomy. Working across U.S. government agencies, industry, and other partners, our multi-disciplinary teams develop foundational measurement science and tools, data-driven standards, reference materials, reference data, and protocols by integrating state-of-the-art automation, analytical methods, and ML/AI as platforms for innovation and standardization. Our work supports various sectors of the bioeconomy, including clinical diagnostics, advanced therapies, agriculture, energy, industrial biotechnology, and production of new biomaterials. Click here for an overview video of the Division.
PRIMARY FOCUS AREAS

Engineering Biology
Rapid advances in the ability to genetically modify biological organisms have advanced a new engineering discipline, commonly referred to as synthetic biology. This approach seeks to harness the power of living systems for a variety of manufacturing applications, such as advanced therapeutics, sustainable fuels, chemical feedstocks, and advanced materials.

Regenerative Medicine and Advanced Therapies (RMAT)
Advanced therapies are demonstrating promising clinical efficacy and could change the paradigm for treating a wide range of diseases and injuries. Clinical translation of this broad class of new therapeutics requires better defined and characterized products and more robust, reliable, and cost-effective manufacturing processes.

Precision Medicine
The conventional approach to medicine is rapidly changing to a data-driven strategy in which therapies are individually targeted to a patient based on genome, physiology, environment, or lifestyle. This approach is revolutionizing health care— especially in the treatment of cancer—but its success depends on using data from bioanalytical measurements with potential wide-ranging biases and uncertainties.

Microbiome
Microbial communities (microbiomes) abound everywhere, forming resilient ecological networks adapted to their environments. Research has connected the behavior of these cooperative communities to beneficial and problematic outcomes in diverse biological systems including: human health, agricultural productivity, water and food safety, waste remediation, and infrastructure corrosion.
Events
News and Updates
Awards
Press Coverage
Taking Measure Blog Post: Sinking Our Teeth Into Science: How Regenerative Medicine Can Help Make Us Healthier
Taking Measure Blog Post: The Promise of Synthetic Cells: Revolutionary New Drugs, Outer Space Explorers and Pushing Beyond the Limits of Evolution
CRISPR Medicine News: Creating the common language of genome editing
Taking Measure Blog Post: NIST Gets Going With the Flow Cytometry Standards Consortium
NIST-FDA Workshop Report: Workshop on Standards for Pathogen Detection via Next-Generation Sequencing
Taking Measure Blog Post: The Rapid Microbial Testing Methods Consortium: Enabling Safe, Effective and Timely Advanced Therapies
Taking Measure Blog Post: Rewritten in Our DNA: Measurements for Genome Editing
Nature: The promise and challenge of therapeutic genome editing
Taking Measure Blog Post: Genome in a Bottle: Spelling Out DNA’s ‘Dark’ Sequences
Taking Measure Blog Post: Say Hello to Our Little Friends: Toward Microbial BiotheraPOOtics and Diagnostics
Contacts
Division Chief
-
(301) 975-6765
Deputy Chief
-
(301) 975-3646
NIST Fellows
-
(301) 975-2447
Administrative Officer and Assistant
-
(301) 975-4896
-
(301) 975-5876
Division Office Manager
-
(301) 975-2629
Division Safety Representative
-
(301) 975-8888
Property Officer
-
(301) 975-8888